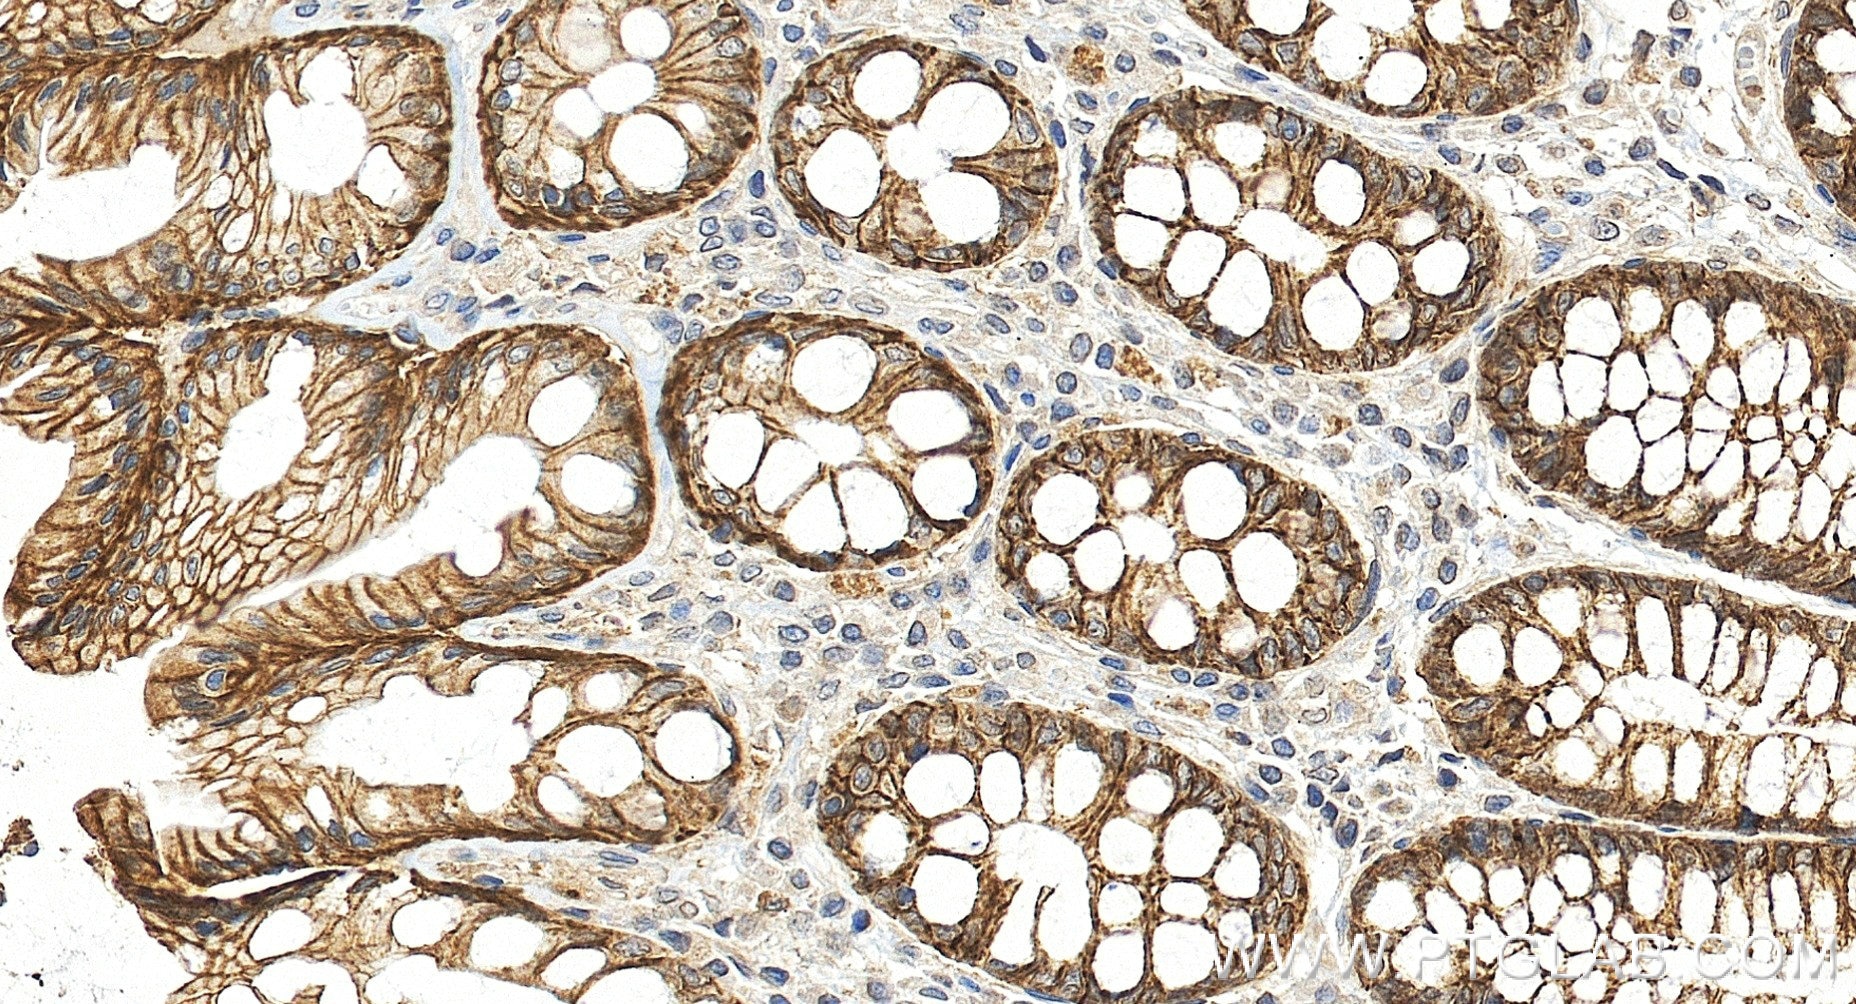
Immunohistochemistry (IHC) staining of human colon tissue using TRPM4 Recombinant monoclonal antibody (87085-1-RR)

Product Information
87085-1-PBS targets TRPM4 in WB, IHC, Indirect ELISA applications and shows reactivity with human samples.
| Tested Reactivity | human |
| Host / Isotype | Rabbit / IgG |
| Class | Recombinant |
| Type | Antibody |
| Immunogen |
Peptide Predict reactive species |
| Full Name | transient receptor potential cation channel, subfamily M, member 4 |
| Calculated Molecular Weight | 1214 aa, 134 kDa |
| Observed Molecular Weight | 130~150 kDa |
| GenBank Accession Number | BC132727 |
| Gene Symbol | TRPM4 |
| Gene ID (NCBI) | 54795 |
| Conjugate | Unconjugated |
| Form | Liquid |
| Purification Method | Protein A purification |
| UNIPROT ID | Q8TD43 |
| Storage Buffer | PBS only, pH 7.3. |
| Storage Conditions | Store at -80°C. |
Background Information
TRPM4 is a Calcium-activated nonselective cation channel. It is activated by increase in intracellular Ca2+, mediates transport of monovalent cations (Na+ > K+ > Cs+ > Li+), leading to depolarize the membrane. It thereby plays a central role in cadiomyocytes, neurons from entorhinal cortex, dorsal root and vomeronasal neurons, endocrine pancreas cells, kidney epithelial cells, cochlea hair cells etc. TRPM4 participates in T-cell activation by modulating Ca2+ oscillations after T lymphocyte activation, which is required for NFAT-dependent IL2 production. It's also involved in myogenic constriction of cerebral arteries.